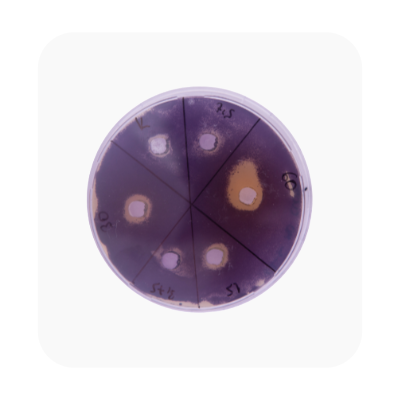
Agar plaat

1. Wat is kolonietelling?
Kolonietelling is een microbiologische techniek die wordt gebruikt om het aantal levende micro-organismen in een monster te bepalen. Denk hierbij aan bacteriën, gisten of schimmels. Deze methode is belangrijk in:
- Onderzoek
- Kwaliteitscontrole
- Voedselveiligheid
Het helpt te beoordelen of een product of watermonster voldoet aan specifieke normen en regelgeving, zoals ISO 4833-1.
Waarom is kolonietelling belangrijk?
Kolonietelling is een essentiële techniek in microbiologie. Het biedt:
- Betrouwbare kwaliteitscontrole: Zekerheid dat producten in de voedsel-, water- en farmaciesector veilig zijn voor gebruik.
- Naleving van regelgeving: Internationale standaarden, zoals ISO 4833-1, vereisen microbiologische tests.
- Nauwkeurige resultaten: Het meten van levende micro-organismen helpt onderzoekers en producenten bij betrouwbare analyses.
2. Hoe werkt kolonietelling?
Bij kolonietelling wordt een monster zoals water, voedsel of een andere stof, eerst verdund en vervolgens op een voedingsbodem aangebracht. Hierna wordt de voedingsbodem geïncubeerd en groeien micro-organismen uit tot zichtbare kolonies.
Het aantal kolonies wordt meestal uitgedrukt in colony-forming units (CFU) per milliliter vloeistof of per gram monster.
Voorbeeld: Stel dat een fles mineraalwater wordt onderzocht en er 50 kolonies worden geteld in een verdunning van 1:10. Dit betekent dat er 500 CFU per milliliter in het water aanwezig zijn.
(Tip: Gebruik altijd een steriele werkomgeving om de nauwkeurigste resultaten te verkrijgen.)
3. Toepassingen van kolonietelling
- Waterkwaliteit: Het meten van microbiologische contaminatie in drinkwater, zwemwater of afvalwater.
Bijvoorbeeld: Bij zwemwater wordt regelmatig kolonietelling gebruikt om te bepalen of het veilig is voor gebruik. - Voedselveiligheid: Het beoordelen van de microbiologische contaminatie in levensmiddelen om houdbaarheid en veiligheid te waarborgen.
- Farmaceutische industrie: Controle op steriele producten en grondstoffen.
- Onderzoek: Het meten van microbiële populaties in verschillende milieus, zoals bodem of lucht.
4. Waarom zou u handmatig tellen als er apparaten beschikbaar zijn?
Het tellen van kolonies is een nauwkeurig en soms tijdrovend proces. Handmatig tellen heeft voordelen, zoals lagere kosten, maar kan vermoeiend en foutgevoelig zijn. Een kolonieteller maakt het proces eenvoudiger, sneller en minder belastend. Hieronder een vergelijking:
Handmatig kolonietellen
- Kosten: Goedkoper, omdat alleen een markeerstift, loep en handteller nodig zijn.
- Efficiëntie: Tijdrovend, vooral bij grote aantallen monsters.
- Gebruiksgemak: Vereist meer inspanning en concentratie.
Kolonieteller
- Kosten: Vereist een hogere investering.
- Efficiëntie: Sneller dankzij ingebouwde functies zoals automatische telling en verlichting.
- Gebruiksgemak: Minder belastend door automatische registratie.

5. Hoe moet u kolonietellen?: Stap voor stap uitgelegd
Hoe moet u handmatig kolonietellen?
- Benodigdheden Loep: Om kolonies nauwkeurig van elkaar te onderscheiden.
- Markeerstift: Voor het stippen van kolonies en het verdelen van de petrischaal in vakjes.
- Handteller: Voor het bijhouden van het aantal kolonies.
- Lichtbron: Voor beter contrast en zichtbaarheid.
Stappenplan
- Voorbereiden van de petrischaal: Verdeel deze in vakjes met een markeerstift. Hieronder staan 3 voorbeelden.
- Plaatsen van de lichtbron (optioneel): Dit verbetert het contrast.
- Tellen met een loep: Werk vakje voor vakje en gebruik de handteller om het aantal bij te houden.
- Controleer en noteer: Noteer het eindgetal en voer indien nodig een tweede controle uit.

Voorbeeld 1

Voorbeeld 2

Voorbeeld 3
Hoe gebruikt u een kolonieteller?
Benodigdheden
- Kolonieteller: Voor automatische telling.
- Petrischaal: Met de te tellen kolonies
- Markeerstift: Voor het markeren van getelde kolonies.
Stappenplan
- Voorbereiding van de petrischaal: Zorg dat de schaal schoon en vrij van condens is.
- Plaatsen van de petrischaal: Leg deze in de kolonieteller.
- Inschakelen: Zet de teller aan en controleer of deze op nul staat.
- Markeren en tellen: Markeer de kolonies terwijl de teller automatisch registreert.
- Controleer en registreer: Noteer het eindgetal en voer een extra controle uit indien nodig.
6. Wet- en regelgeving: ISO 4833-1
ISO 4833-1 is een internationale standaard die richtlijnen biedt voor het tellen van aerobe micro-organismen in voedingsmiddelen en diervoeder.
Voorbeeld: Een voedingslaboratorium test melkproducten met ISO 4833-1 om ervoor te zorgen dat deze voldoen aan internationale veiligheidsnormen voor consumptie.
Deze standaard is wereldwijd erkend en essentieel voor het waarborgen van microbiologische veiligheid en kwaliteitscontrole.
7. VIDEO: Handmatig tellen & tellen met een kolonieteller
*Zet cookies aan om de video's te bekijken.
Videovoorbeeld: Handmatige kolonietelling
Videovoorbeeld: Kolonieteller
Conclusie
Kolonietelling is een fundamentele techniek in microbiologie die een cruciale rol speelt in onderzoek, kwaliteitscontrole en voedselveiligheid. Of u nu handmatig telt of gebruikmaakt van een geavanceerde kolonieteller, het doel blijft hetzelfde: nauwkeurige en betrouwbare resultaten behalen.
Handmatig tellen biedt een kosteneffectieve optie, maar vereist meer tijd en concentratie. Een kolonieteller daarentegen maakt het proces efficiënter en minder foutgevoelig, wat vooral waardevol is bij grote aantallen monsters.
Door de stappen en richtlijnen in deze tekst te volgen, kunt u kolonietelling correct en effectief uitvoeren. Vergeet niet om veelvoorkomende fouten te vermijden door steriel te werken, nauwkeurige verdunningen te maken en geschikte apparatuur te gebruiken. Met standaarden zoals ISO 4833-1 blijft kolonietelling een essentiële techniek om de veiligheid en kwaliteit van producten wereldwijd te waarborgen.
Door deze kennis toe te passen, draagt u bij aan betrouwbaar microbiologisch onderzoek en naleving van belangrijke regelgeving.

